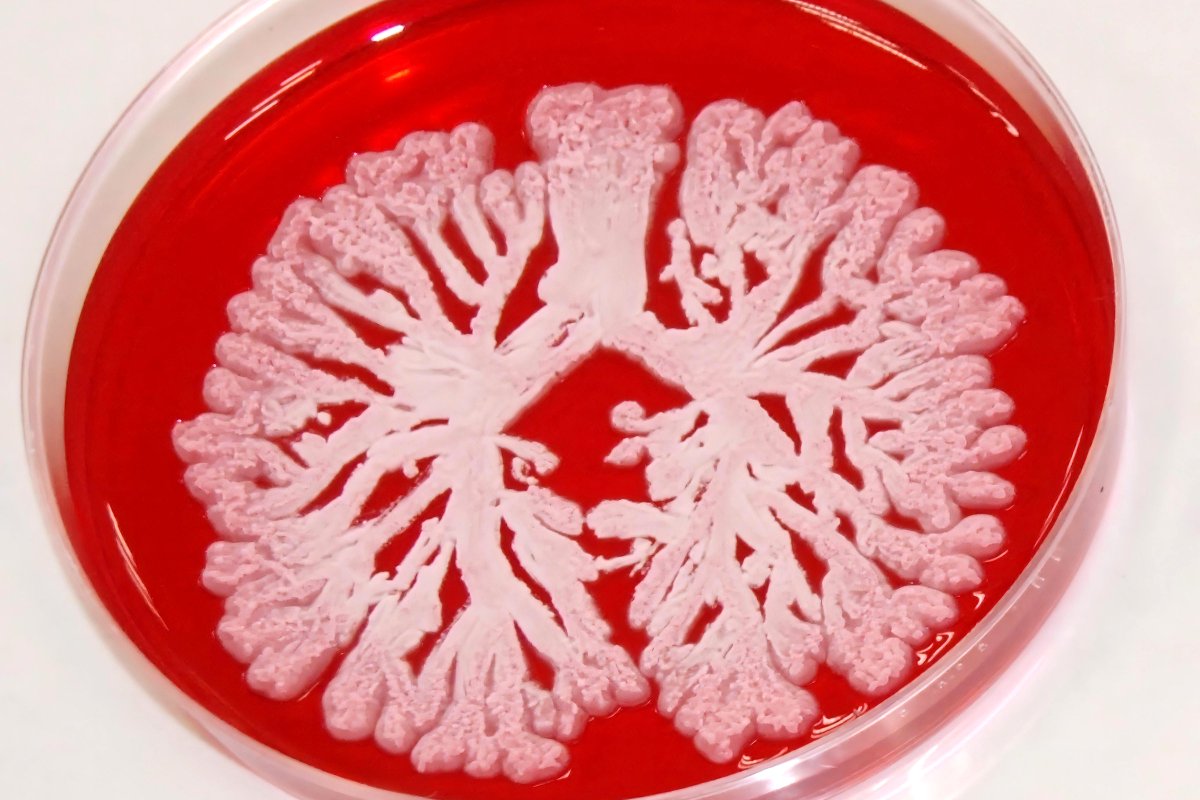
MilliporeSigma tweet media

Jennifer Scott
256 posts


My bars are moving they didn’t move last time!!! I have too many to count ! #Glastonbury
English

@Danni_Onlyme @MartinSLewis Which way do you think? I've just spent 10 months trying to sort out my visa to work in Portugal 😅 and I'm from the UK. There are so many incredible research groups in Europe, and currently, people from the UK have to jump through so many hoops to work for them.
English

RT @PinkPetri: There is a major lack of microbial/music parody stickers. Thankfully I'm here to change that!
pinkpetri.etsy.com http…
English

@secretglasto Thank youuuu!! Lianne La Havas is incredible 😍
English

@midwifeingreen @secretglasto Yes, but not sure if he'll do any more sets or how big they'll be if he does (if they're little they'll probably keep it off here for safety concerns). Although I'm crossing my fingers something will drop 🤣
English

Last year we asked who Pizza Hotline was. Find out at Arcadia's Bug 2000 tonight.
Secretglasto@secretglasto
Who is Pizza Hotline?
English

@TommyMagro89 @secretglasto They addressed this in a podcast. There's a team of them! It sounded like some years they don't all get tickets, and if they do they bring someone new onto the team. That way, there's always someone off-site to keep things running smoothly while the others enjoy the festival 🙌
English

@secretglasto Just a question, do u get given tickets every year or how on earth are u getting in without fail everytime 😂
English

@dandavis101 A little late (hope you caught them!), but for the future Glendale on Telegram is probably the best bet! t.me/GlendaleApp
English

Is there an app which will wake me up if or when they appear? #northernlights #Auroraborealis
English

RT @LIFEworldwide: Eleven fully-funded PhDs available at MYCOS, Innsbruck. Topics include: azole burden, azole resistance and alternative t…
English

RT @UofMMFIG: One of the latest MFIG papers in collaboration with @MycologyRefManc on a novel mycobiome diagnostic in @BioMedCentral
http…
English

RT @SlavenaVylkova: Hi all! Many scientists draw inspiration from art and vice versa. I am working on an event that will showcase the artis…
English

RT @ElaineBignell: Final call for abstracts for #HFP2024, a lecture course designed to bring early career researchers together with experts…
English

@michhulin Hope you all have a safe journey!! What an amazing way to start the new year 🙌🥳
English

RT @toni_gabaldon: Interested in joining us at @gabaldonlab ? Reach out to us!
English
Jennifer Scott รีทวีตแล้ว

🚨 We are recruiting! 2 x Senior lab technician posts (NHS Band 5) at the @NIHRresearch Centre for Precision Approaches to Combatting AMR at @MFTnhs, lead by @timwfelton
Interested in joining us? Apply here: mft.nhs.uk/careers/search…
Deadline 26th Nov ⌛
English
Jennifer Scott รีทวีตแล้ว

Me advocating for the relevance of azole persistence in the treatment failure of A. fumigatus infections
#timm2023
(shameless self promotion of the work 😁)

English

We want to see your out-of-the-world agar art! This year's @ASMicrobiology Agar Art Contest theme is Microbiology in Space. The winner wins a trip to our Molsheim, France, site for a special "Agar Art on Display” event.
Submissions close on October 27: ms.spr.ly/60119xVdV

English



